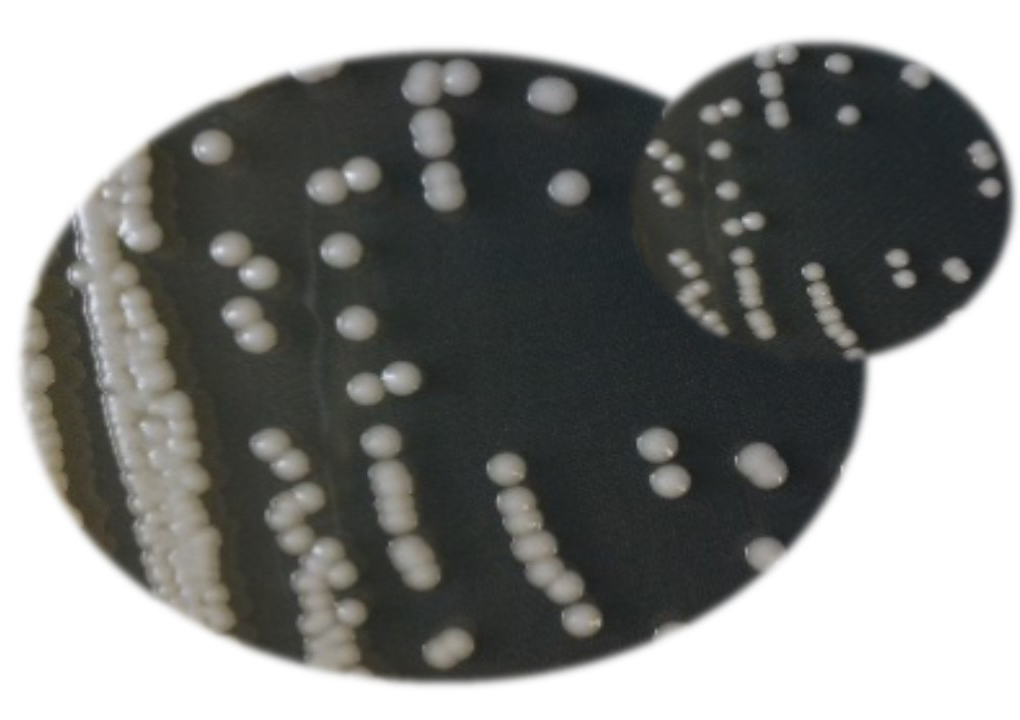
4 โปรตีนลูกผสม Recombinant protein

โปรตีนลูกผสม (Recombinant protein) คือ โปรตีนที่เกิดจากการผลิตโดยเซลล์เจ้าบ้านที่ปรับปรุงพันธุกรรมเพื่อการผลิตโปรตีนในปริมาณสูง และสามารถพัฒนากระบวนการผลิตในภาคอุตสาหกรรมได้ ปัจจุบันประเทศไทยยังไม่มีความสามารถในการผลิตโปรตีนลูกผสมระดับอุตสาหกรรม ทำให้ต้องนำเข้าโปรตีนลูกผสม เช่น เอนไซม์ เพื่อนำมาใช้ในอุตสาหกรรมที่เกี่ยวข้อง ส่งผลให้ประเทศขาดดุลการค้าเป็นจำนวนมาก แม้ว่าประเทศไทยจะมีข้อได้เปรียบด้านความหลากหลายทางชีวภาพของจุลินทรีย์ซึ่งเป็นแหล่งสำคัญที่สร้างโปรตีนและชีวภัณฑ์ต่าง ๆ ที่เป็นประโยชน์ แต่ที่ผ่านมาการผลิตโปรตีนจากจุลินทรีย์ตามธรรมชาติมักมีปัญหาการเจริญเติบโตช้า ได้โปรตีนเป้าหมายในปริมาณต่ำและต้นทุนสูง นอกจากนี้ ยังขาดการพัฒนาจุลินทรีย์เพื่อนำมาใช้เป็นเซลล์เจ้าบ้านที่มีประสิทธิภาพสูงเพื่อการผลิตโปรตีนลูกผสมที่มีอิสระในการดำเนินการ (Freedom to operate)
ศูนย์พันธุวิศวกรรมและเทคโนโลยีชีวภาพแห่งชาติ (ไบโอเทค) สำนักงานพัฒนาวิทยาศาสตร์และเทคโนโลยีแห่งชาติ (สวทช.) กระทรวงการอุดมศึกษา วิทยาศาสตร์ วิจัยและนวัตกรรม (อว.) นำโดย ดร.นิรันดร์ รุ่งสว่าง นายเอกชัย ภูสีน้ำ และ ดร.สุทิพา ธนพงศ์พิพัฒน์ ทีมวิจัยระบบจุลินทรีย์เพื่อผลิตชีวโมเลกุล สามารถพัฒนาเทคโนโลยีการผลิตโปรตีนลูกผสมจากจุลินทรีย์ ได้แก่ ยีสต์ทนร้อนสายพันธุ์ไทยที่มีประสิทธิภาพสูง เจริญเติบโตได้ดีในช่วงอุณหภูมิกว้าง และใช้แหล่งคาร์บอนราคาถูกได้หลายชนิด เช่น น้ำตาลทราย และกากน้ำตาล จึงช่วยลดต้นทุนการผลิตลงได้มากเมื่อเปรียบเทียบกับยีสต์สายพันธุ์ทางการค้า ปัจจุบันนักวิจัยได้พัฒนาการผลิตโปรตีนลูกผสมออกนอกเซลล์ ซึ่งจะสามารถนำยีสต์ทนร้อนไปใช้ประโยชน์ในระดับอุตสาหกรรมได้อย่างกว้างขวาง โดยระบบดังกล่าวเป็นระบบที่มีความปลอดภัย ไม่ติดทรัพย์สินทางปัญญา และปลอดจากการขออนุญาตใช้สิทธิจากต่างประเทศ

ดร.นิรันดร์ รุ่งสว่าง นักวิจัยอาวุโส ไบโอเทค เปิดเผยว่า ระบบการผลิตโปรตีนลูกผสมจากยีสต์ทนร้อนสายพันธุ์ไทยที่พัฒนาขึ้นนี้ มีจุดเด่นคือ มีประสิทธิภาพสูงในการผลิตโปรตีนลูกผสมชนิดต่าง ๆ ที่มีความต้องการทางอุตสาหกรรม เป็นระบบที่มีความปลอดภัย ทนร้อนได้สูง มีความจำเพาะกับวัตถุดิบราคาถูก ไม่ติดสิทธิต่างประเทศ มีอิสระในการดำเนินการ มีต้นแบบผลิตภัณฑ์ และผลิตโปรตีนลูกผสมต้นแบบได้หลากหลายชนิด อาทิ เอนไซม์ไซแลนเนส เอนไซม์ไฟเตส อินเตอร์เฟอรอล และโปรตีนแคปสิดของไวรัส การคิดค้นและพัฒนางานวิจัยนี้จะเป็นประโยชน์ต่อผู้ประกอบการในอุตสาหกรรมพลังงานและเคมีชีวภาพ อุตสาหกรรมอาหาร อุตสาหกรรมส่วนผสมฟังก์ชั่น และอุตสาหกรรมยาชีววัตถุสำหรับคนและสัตว์
เผยแพร่ข่าว : นางสาวพรชิตา รุกขชาติ
กลุ่มสื่อสารองค์กร กองกลาง
กระทรวงการอุดมศึกษา วิทยาศาสตร์ วิจัยและนวัตกรรม
โทรศัพท์ 0 2333 3700 ต่อ 3972 โทรสาร 0 2333 3834
e-mail : pr@mhesi.go.th
Facebook : @MHESIThailand
Twiiter : @MHESIThailand
Call Center โทร.1313
![]()
กระทรวงการอุดมศึกษา วิทยาศาสตร์ วิจัยและนวัตกรรม (อว.)
เป็นหน่วยงานของรัฐที่จัดตั้งขึ้นเพื่อขับเคลื่อนการอุดมศึกษาไทย วิทยาศาสตร์ วิจัยและนวัตกรรม ไปสู่มาตรฐานในระดับสากล และเพิ่มอันดับความสามารถการแข่งขันในระดับนานาชาติอย่างยั่งยืน ไม่ได้มีวัตถุประสงค์เพื่อแสวงหากำไร หากท่านพบว่ามีข้อมูลใดๆ ที่ละเมิดทรัพย์สินทางปัญญาปรากฏอยู่ในเว็บไซต์นี้ โปรดแจ้งให้ทราบ เพื่อดำเนินการแก้ปัญหาดังกล่าวโดยเร็วที่สุดต่อไป
© 2020 Ministry of Higher Education, Science, Research and Innovation. ALL RIGHTS RESERVED.